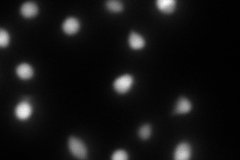
YPL128C
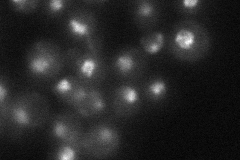
YPL128C

View description
Telobox-containing general regulatory factor; binds to TTAGGG repeats within subtelomeric anti-silencing regions (STARs) and possibly throughout the genome and mediates their insulating capacity by blocking silent chromatin propagation
Localization:
Intensity:
Fold change:
Significance:
-
C’ GFP library in SD

nucleus37.15 -
N' NOP1pr-GFP in SD

nucleus100.563 -
N' TEF2pr-mCherry in SD
nucleus133.259 -
N' NATIVEpr-GFP in SD
punctate,nucleus29.5336 -
N' TEF2pr-VC and Cyto-VN in SD

#N/A0 -
C’ GFP library in SD+DTT

nucleus39.971.07No -
C’ GFP library in SD+H2O2

nucleus37.571.01No -
C’ GFP library in Starvation Media

nucleus36.910.99No -
C’ GFP library on the background of Pup2-DaMP

nucleus -
C’ GFP library on the background of CCT mutant

nucleus37.42691.00731No
